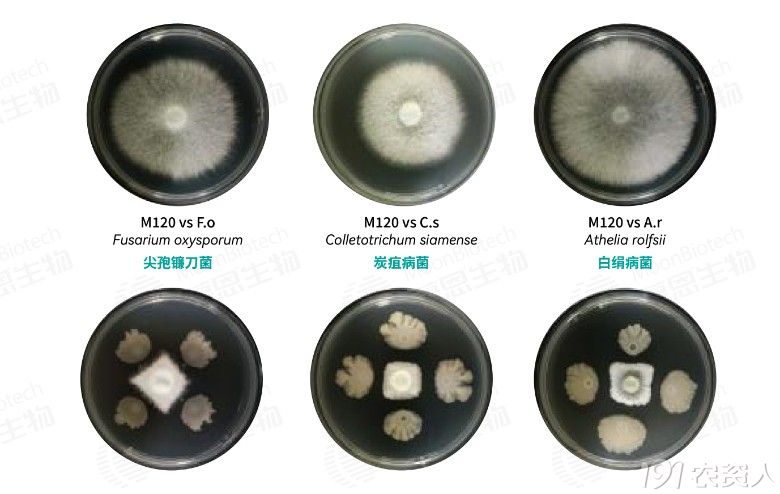

直面产业痛点,慕恩生物依托全球领先的微生物发掘与生物制造平台,重磅推出微微一动®复合液体微生物菌剂。产品采用罗氏甲基红杆菌M520+枯草芽孢杆菌M120双菌复配,集抑菌、防线、促生、改土四位一体,强力激活土壤微生态,壮根提质促丰收。

(一)双菌协同,1+1>2
枯草芽孢杆菌M120
广谱抑菌,激活根系内生动力
- 抑菌防病:强力抑制尖孢镰刀菌、炭疽病菌、白绢病菌、立枯丝核菌等多种病原菌,减少土传病害发生,构建根系生长健康环境。
- 促生提质:M120能自主合成分泌生长激素IAA,促根系生长,增强水肥吸收与抗倒伏能力,同步调控植株分化发育,提高坐果质量。
- 营养赋能:菌株代谢产生超过10种可吸收氨基酸,并螯合中微量元素促进养分汲取,持续为根系补给营养,加强作物抗逆。
M120抑制病原菌(平板对峙) | 图源:慕恩生物
罗氏甲基红杆菌M520
防线固氮,活化土壤提升地力
- 安全抑线:M520生成的多种挥发性代谢产物VOCs,作用于根结线虫不同生长阶段,抑制其活动与繁殖,从而阻断侵染路径,大幅压低土壤线虫基数;可与化药搭配使用,降低线虫抗药性风险,实现生物+化学协同增效。

M520抑制根结线虫 | 图源:慕恩生物
- 铁素争夺:通过分泌高活性铁载体,络合环境中的铁离子,让病原菌因“铁饥饿”无法繁殖,同时为作物提供专属“补铁剂”,优化抑菌促生效果。
- 生物固氮:将空气中的氮气转化为作物可直接吸收利用的硝态氮,提升肥料利用率,减少化肥施用,缓解土壤退化问题。
(二)三重优势,种植无忧
01 高活高效,快速起效
产品每毫升含10亿+活菌,液体剂型锁活保效,施用后快速定植发挥功能。
02四位一体,全面呵护
“防线+促生+抑菌+改土”四大功效,一站式满足根系养护与土壤调理需求。
03施用灵活,省工省本
适配滴灌、冲施、叶喷、蘸根多种场景,用量少、效果佳,降低综合成本。
(三)科学实证,效果出众

黄瓜苗使用微微一动®100倍稀释液浇灌,地上、地下单株干重显著增长,植株健壮、株型均衡,为后期高产打下坚实基础。

大田淋根试验(5L/亩)显示,施用7天后,微微一动®处理组叶片面积、生长速率等均显著优于对照组,促生效果表现突出。
双菌复配 强根固本
活菌养地 修复生态
抑菌防线 全程守护
绿色安全 提质增产
